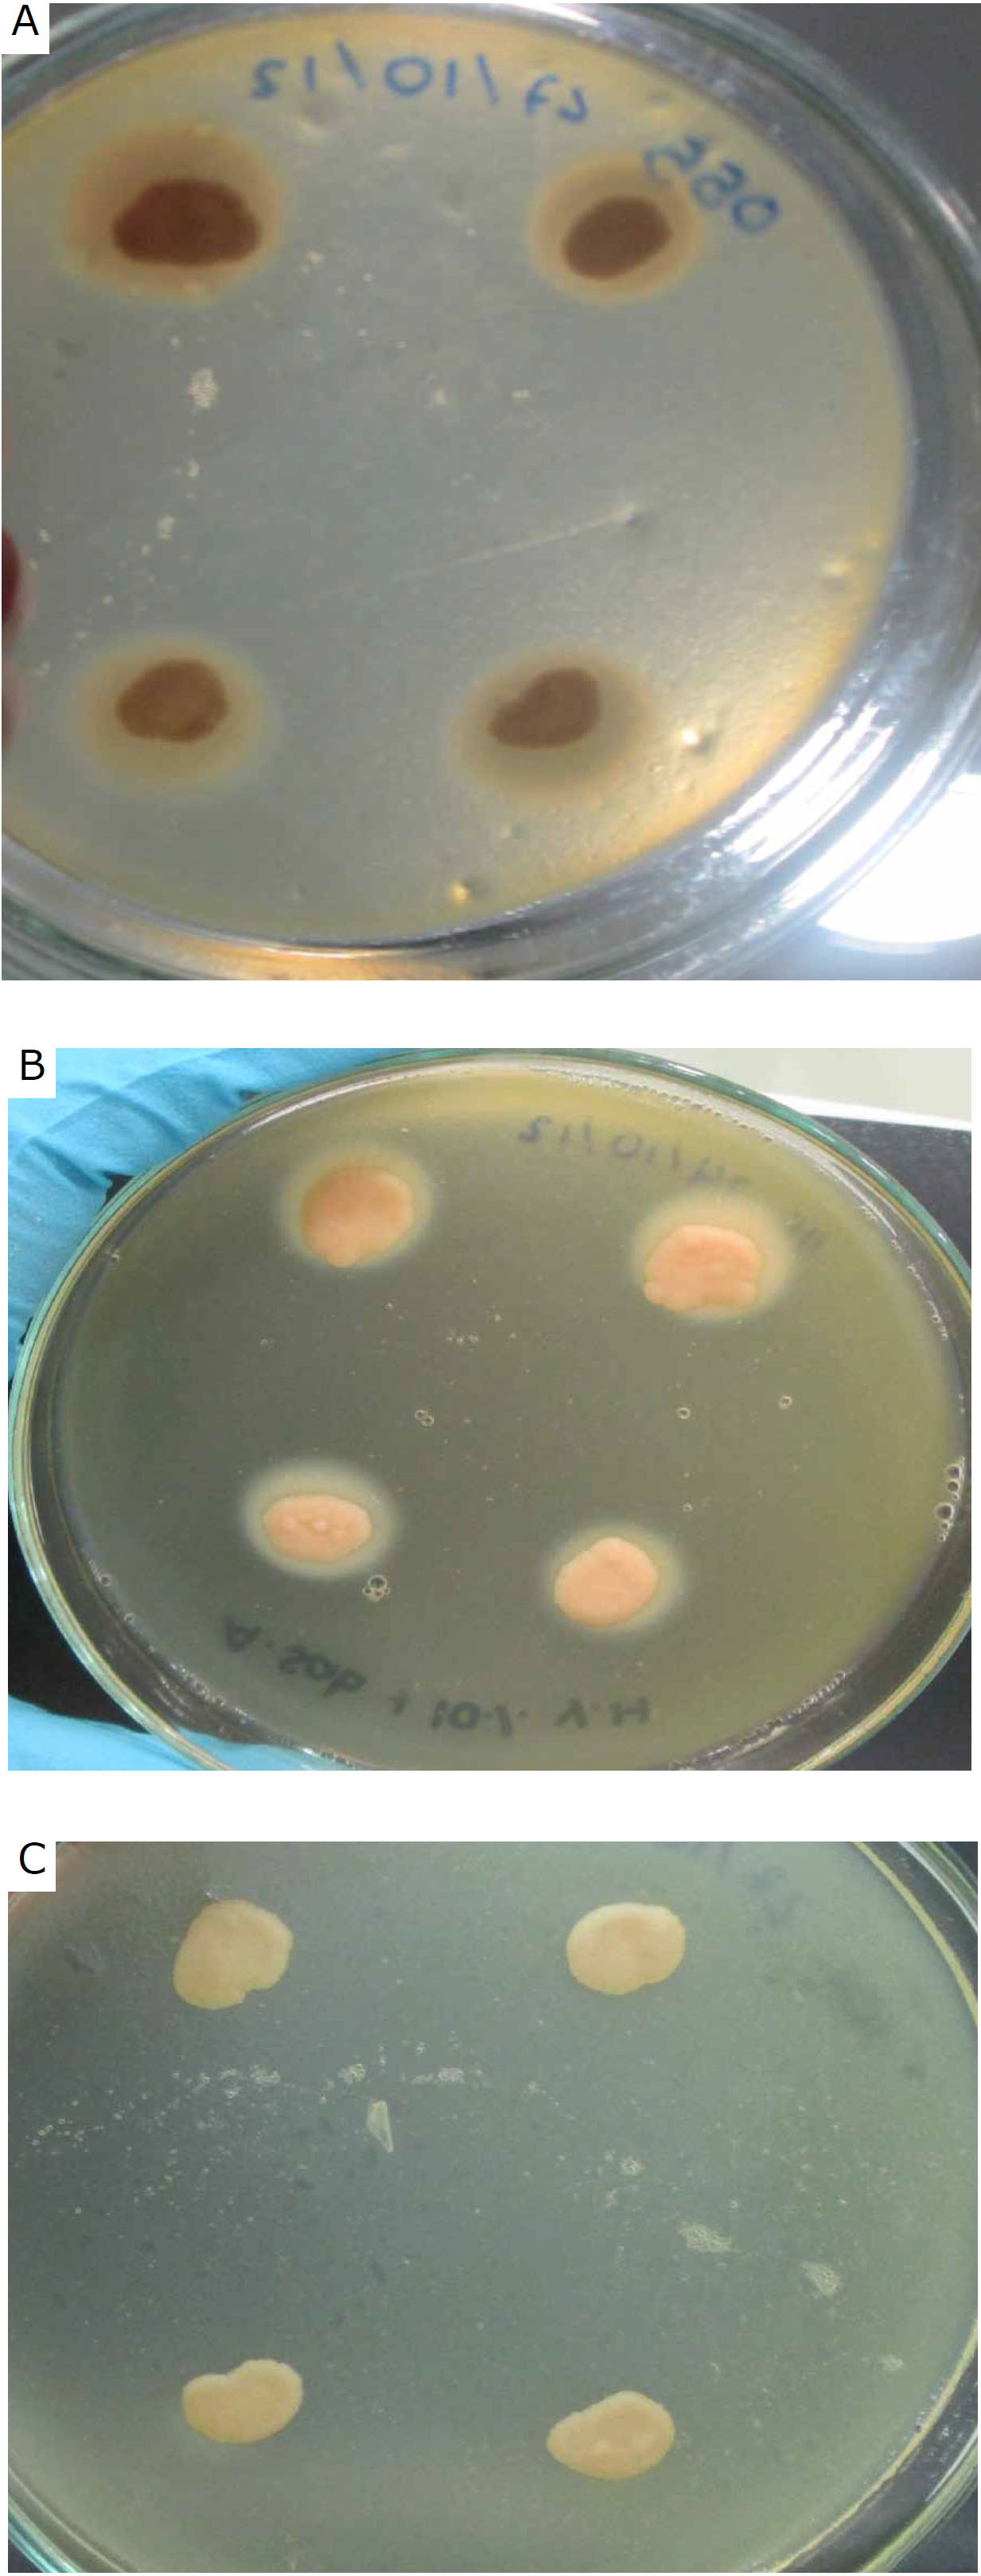
Canine Malassezia phospholipase activity. A Very high activity. B High activity. C No activity.

Phenotypic characterization of canine Malassezia spp., isolates
Caracterización fenotípica de aislamientos de Malassezia spp., de origen canino
Phenotypic characterization of canine Malassezia spp., isolates
Revista MVZ Córdoba, vol. 21, no. 3, pp. 5535-5546, 2016
Universidad de Córdoba
Accepted: 10 August February 2015
Abstract: Objective. To characterize and identify yeasts of the genus Malassezia by phenotypic features. Materials and methods. First, the macroscopic and microscopic morphological characteristics were described. In addition we performed biochemical and physiological assays as Tweens and Cremophor, including more. Results. Our results evidenced of 105 isolates obtained from dogs diagnosed with external otitis, it was possible to identify two distinct species from 46 isolates within the Malassezia genus: 36.19% (n=38) were identified as M. pachydermatis and 7.62% (n=8) as M. furfur. According to phenotypic patterns the remaining 56.19% (n=59) were reported as Malassezia spp., possibly corresponding to M. furfur and/or M. pachydermatis. Conclusions. Results emphasize the necessity to characterize according to species. It is not feasible to define Malassezia by species based on morphological, biochemical, and physiological findings. Therefore, molecular genotyping should be performed to identify markers allowing a more precise isolate identification. This would broaden our epidemiological knowledge regarding different species involved in canine otitis pathologies. .
Keywords: Biochemical techniques, external otitis, Malassezia, morphology.
Resumen: Objetivo. Caracterizar e identificar levaduras del género Malassezia, mediante características fenotípicas. Materiales y métodos. Inicialmente se describieron las caracteísticas morfológicas macroscópicas y microscópicas, adicionalmente se realizaron pruebas bioquímicas y fisiológicas como Tween y Cremophor, entre otras. Resultados. De 105 aislamientos de caninos diagnosticados previamente con otitis, 46 fueron caracterizados hasta especie, así: El 36.19% (n=38) correspondió a M. pachydermatis, el 7.2% (n=8) a M. furfur; y 56.19% (n=59) restante fueron reportados como Malassezia spp., debido a los patrones fenotípicos atípicos que presentaron, y que podrían corresponder a variantes de M. furfur y/o M. pachydermatis. Conclusión. Estos resultados enfatizan la necesidad de hacer una caracterización a nivel de especie y/o genotipos mediante marcadores moleculares que permitan una identificación más precisa de los aislamientos. Con el presente estudio, se contribuye al conocimiento de las diferentes especies involucradas en patologías óticas en caninos..
Palabras clave: Malassezia, morfología, otitis externa, pruebas bioquímicas.
INTRODUCTION
Yeast of the genus Malassezia are found as commensal cutaneous microbiota in humans, as well as the external auditory canal in dogs. None the less, under humidity conditions, sweating, obstruction, keratinization disorders, and immunosupression, among others, they can cause diverse pathologies (1, 2, 3, 4). In dogs the main diseases associated with these microorganisms are external otitis (EO) and dermatitis, with M. pachydermatis as the most frequent species reported. However, M. furfur has also been reported in patients with otic symptoms (5,6).
Prevalence of EO in dogs is between 10 - 20% (7, 8, 9), with its diagnosis based on clinical history or cytological findings (7,10). The gold standard assay is cell culture; however it is not a routine lab test. None the less, microbiological support is fundamental to define the etiology associated with these processes, as well as to contribute to epidemiology and clinical manifestations of this pathology.
In contrast to other species M. pachydermatis is a nonobligatory lipophylic. This yeast can grow in culture media devoid of lipids, such as Sabouraud’s agar (1,11,12, 13). Media utilized for obligatory lipophylic species isolation are modified Dixon agar and Leeming & Notman, containing Tween, glycerol, and oleic acid as lipid sources for yeast proliferation (11,12).
Malassezia spp. identification is performed by macroscopic morphological characterization of colony size, color, texture, surface, and margin. Microscopic measurements and biochemical and physiological findings confirm macroscopic findings. Among biochemical tests are catalase, β-glucosidase, proliferation on Sabouraud’s agar without lipid supplements, Tween and Cremophor-EL assimilation, phospholipase activity, and pigment production in media with tryptophan as only source of nitrogen. Last, temperature dependant growth is also evaluated at 37°C and 40°C (2,12,13).
Other biochemical tests include positive urea reaction, which allows classifying yeasts of the genus Malassezia within the phylum Basidiomycota (14). Furthermore, catalase negative reaction permits to distinguish M. restricta from all other species within the genus (3,4,12). Other assays based on enzyme activity are phospholipase, hydrolyzing specific ester bonds in glycerophospholipids (15,16). In addition, tryptophan aminotransferase (TAM 1), in charge of tryptophan transamination yielding indol pyruvate; reacts spontaneously with remaining tryptophan molecules producing pigment (17). This enzyme has been widely studied by Zuther et al (18), in the fungus Ustilago maydis. In their work they demonstrated generated indolic pigments are identical to those produced by M. furfur, suggesting this enzyme could be involved in pigment production. Last, lipid assimilation assays evaluate yeast capacity to metabolize supplements of greater or lesser structural complexity such as Tween 20, 40, 60, 80 and Cremophor EL (3,12,13,19,20).
Moreover, physiological tests comprise temperature dependent growth, with 32°C being an optimal temperature. However, some species associated with dog skin pathologies can develop at greater temperatures. As a case in point, M. pachydermatis has the capacity to grow at 37°C and 40°C. In addition, M. furfur can proliferate at 41°C (12,21).
Taking into account EO in dogs has not established cell culture as a routine test, the objective of this work was to identify morphologically and biochemically Malassezia spp. from swab samples in dogs with EO.
MATERIALS AND METHODS
Microorganisms. From collected yeast samples stored at -80°C obtained from auditory canals in dogs diagnosed with EO from four veterinary clinics in Bogotá, 105 Malassezia isolates were characterized. All results were compared to reactions obtained from Centralbureau voor Schimmelcultures (CBS) reference strains: Malassezia furfur CBS 7019, Malassezia pachydermatis CBS 1879, Malassezia sympodialis CBS 7222, Malassezia slooffiae CBS 7956, and Malassezia globosa CBS 7966. Additionally, phospholipase positive control strains were Candida albicans ATCC 90028, Candida krusei ATCC 6258, and Candida parapsilosis ATCC 22019.
Morphological characterization. For morphological evaluation the isolates were thawed and reactivated in modified Dixon agar (two picks) and incubated at 32°C for 5 - 7 days. Macroscopic analysis was based on colony diameter measured in 10 isolated colonies from streaked dilutions. In addition, morphological characterization was performed according to color, texture, and margin. Microscopic evaluation included Gram stain performed from a fresh yeast suspension, to determine length and width (μm). Yeast without budding and with budding were included, for which the parent cell size was registered. Measurements in 30 yeast preparations were carried out by micrometry on both directions: length and width at 100 X (22).
Biochemical and physiological characterization. Biochemical and physiological tests were carried out to identify and characterize yeast from the genus Malassezia including enzymatic activities for catalase, urease, β-glucosidase, and phospholipase (2,3,12,15,16,19). In addition, pigment production in media with tryptophan as only source of nitrogen was also performed (23).
Except for M. pachydermatis, the remaining species in the Malassezia genus use lipids as a carbon source. Thus, lipid supplement assimilation in Cremophor EL (Sigma – USA) and different Tween 40 and 20 (Merck – Germany); Tween 60 and 80 (Sigma – USA) was used to define distinct species. Last, temperature dependant growth was also evaluated at 37°C and 40°C.
For phospholipase activity Sabouraud’s agar was ammended with 10% egg yolk. The medium was inoculated from fresh cultures directly at four different points in the Petri dish, and incubated at 32°C for 21 days. To determine phospholipase activity the ratio of colony diameter to diameter of the dense white zone of precipitation around phospholipase positive colonies (Pz value) was used (15,16,24). No phospholipase activity was considered for a Pz value of 1 (Pz=1). High between 0.64 – 0.99, and very high for Pz values less than 0.64 (15,24). Reading was performed after three weeks of culture averaging Pz values from the four different points of seeding.
For pigment production in media with tryptophan we employed Dixon agar with 0.6% L-trp. (Sigma - USA) (23). Petri plates were incubated at 32°C for 15 days, and the assay was positive if a brown diffusing stain was present on the media.
Statistical analysis. Data obtained from morphological analysis were analyzed with descriptive statistics taking into account central tendency and dispersion as a mean (X) and standard deviation (SD) and variation coefficient (VC), with values less than 15% considered acceptable (25), indicating data did not show large differences between them
RESULTS
Morphological characterization. All morphological characteristics performed in this study are detailed in table 1. Colonies with flat elevation, shiny and entire or undulate margins presented variability within the characterization, thus we were unable to group them according to pattern description

Clinical isolate microscopic characterization did not demonstrate any difference among measurements with Gram stain and fresh yeast suspension, hence only Gram stain measurements are presented in table 2.

Biochemical characterization. Positive urease activity for all CBS referenced strains and for 100% (n=105) isolates (Table 3) confirms their classification in the Basidiomycota phylum (14). Biochemical characterization is summarized in table 3. Based on the biochemical profile 38 isolates corresponded to M. pachydermatis, 8 to M. furfur, and the remaining 59 could not be classified to the species level. Tables 1 – 3 describe morphological and biochemical characterization in detail for each species identified.

DISCUSSION
After test analysis for morphological, biochemical, and physiological characterization, 36.19% (n=38) isolates were identified as M. pachydermatis and 7.62 % (n=8) as M. furfur. The remaining 56.19% (n=59) isolates could not be identified at the species level, given the profiles did not coincide with those reported in the literature (11,14, 19), nor with reactions presented for CBS reference strains.
Morphological, macroscopic, and microscopic characterization. According to macroscopic characterization based on reports by Torres et al (4), 78.3% (n=29) (Table 1) of isolates obtained from dogs in the clinic were identified as M. pachydermatis, they described opaque witish colonies, sometimes umbilicated with an average size of 4 - 5 mm (4). These results also agree with those reported by Guého-Kellermann et al (12) and Guiého et al (13), who defined entire margins or slightly undulated. None the less, some differences were established with the reference strain M. pachydermatis CBS 1879, presenting opaque colonies, convex, witish with smooth surface with entire margins with an average size of 4 ± 1mm (VC = 6.45%).
In a first group identified as M. furfur, 37.5% (n=3) coincided with the morphology observed in M. furfur CBS 7019, with characteristics described by Guehó et al (12,13) for this species: witish colonies, smooth, with umbonate elevation, entire margins or slightly irregular with an average size of 5 mm (12). In contrast, the second group 37.5% (n=3) agrees with reports from Crespo et al (3), who described witish colonies, smooth or slightly rough with a 4–5 mm diameter (3). The remaining 25% presented variable macroscopic characteristics including flat elevation, undulate margins, corresponding partially to some reports (21).
Although 59 Malassezia spp., isolates shared some macroscopic features with M. furfur and/or M. pachydermatis, these were insufficient to characterize them up to species level, since biochemical tests presented atypical patterns for these two species (4,12).
Microscopic characterization of isolates identified as M. pachydermatis, evidenced oval cells and differences in measurements as compared to reports by Guillot et al (26), Dos Santos et al (21), and Guého-Kellermann et al (12), who described for this species oval cells with lengths between 4 – 5 μm and widths between 2 – 2.5 μm (12,21,26), as observed for the reference strain M. pachydermatis CBS 1879, with a mean cell length of 4.1 μm and 1.8 μm for cell width.
M. furfur isolates evidenced oval and cylindrical shaped cells of different sizes. This variability in shape concurs with pleomorphism reported for this species (3,12,21). Additionally, Crespo et al (3) reported average sizes of 4–6 μm. However, Dos Santos et al (21), and Guého-Kellermann et al (12) reported lengths up to 8 μm and widths of 1.5 – 3 μm, agreeing with the results here obtained. The average length for the reference strain M. furfur CBS 7019, was 5.48 μm and an average width of 2.0 μm.
Likewise, Malassezia spp., isolates microscopic characterization demonstrated attributes similar to those identified in M. furfur and M. pachydermatis in terms of morphological variability and cell size.
Colony measurement descriptive analysis suggests their sizes did not differ between species. Due to contrasting morphological characteristics present within species, morphometric parameters cannot be used as a guide to define distinct species within the Malassezia genus.
Biochemical and physiological characterization. According to biochemical characterization, catalase test was positive for all CBS reference strains and 100% isolates. This allowed inferring none of the clinical isolates was M. restricta (3,4,12).
Out of the 38 clinical isolates identified as M. pachydermatis, only 11 were positive for bile esculine. This variability in β-glucosidase production has been reported for M. pachydermatis by Ashbee (2), Hossain et al (27), and Guého-Kellermann et al (12). This activity was also present for three M. furfur isolates, in agreement with reports from Mayser et al (19) and Guého-Kellermann et al (12), who describe M. furfur is capable of hydrolyzing esculine. Out of the remaining 59 Malassezia spp. samples, 21 were positive for bile esculine. This results confirm in this study esculine hydrolysis cannot be used to distinguish differences among species. In contrast, it can be used to distinguish between M. sympodialis and M. slooffiae, with the first one being positive for bile esculine (12).
The 105 evaluated isolates had different growth characteristics in presence of Cremophor EL and Tween 20, 40, 60, and 80, lipid supplements. According to Mayser et al (19), Cremophor EL is a test distinguishing M. furfur from other species. In this study, it was evidenced M. furfur CBS 7019 was the only reference species that had a positive reaction. None the less, Ashbee (2) and Guého-Kellermann et al (12) described variability in assimilation pattern for M. furfur and M. pachydermatis. In a study evaluating genetic variability, Hossain et al (27) confirmed Cremophor EL in 66% of the isolates studied. Based on these reports, the data here presented can be classified as M. pachydermatis and M. furfur.
With respect to Tween assimilation Ashbee (2) and Guého-Kellermann et al (12) proved M. pachydermatis is capable of Tween 20 assimilation, as was observed in 15.79% (n=6) of our isolates. However, 84.21% (n=32) and reference strain CBS 1879 did not assimilate Tween 20, as exemplified by Torres et al (4), and Crespo et al (3).
For M. furfur isolates, 75% (n=6) assimilated all Tweens, as reported by Crespo et al (3), Torres et al (4), and Guého-Kellermann et al (12). In addition, CBS 7019 reference strain was also capable of assimilating all Tweens. Never the less, 25% (n=2) assimilated only Tween 40, 60, and 80, a variation reported by Batra et al (28). Malassezia spp. exhibited different lipid supplement assimilation patterns. Therefore, they were grouped as follows: Group A (n=7) Tween 20, 60, and 80 assimilation; Group B (n=15) Tween 60 and 80 assimilation; Group C (n=9) due to increased variability it was not possible to classify. One of the isolates was unable to assimilate any Tween, thus it could correspond to M. globosa, however we did not observe the characteristic cerebriform colony morphology for this species.
The only species that did not present growth on Sabouraud’s agar without lipid supplements was M. pachydermatis CBS 1879. This has been reported by different authors describing M. pachydermatis as the only nonbligatory lipohylic species within the genus (12,13). Likewise, clinical isolates compatible with M. pachydermatis grew on Sabouraud’s agar. In addition, due to all Tween assimilation or Tween 40, 60, and 80 assimilation it was possibly to classify them as M. pachydermatis.
In regards to Malassezia spp. 61% could grow on Sabouraud’s agar, classifying them as atypical M. pachydermatis (12,13,26), although it should be taken into account that Cafarchia et al (29) reported lipodependent phenotypes for this species. In addition to other test results, such as Cremophor EL assimilation it was not possible to identify as M. pachydermatis with certainty.
Phospholipase activity was positive for all reference strains. Highest values were observed for M. furfur CBS 7019 (Pz=0.66) and M. pachydermatis CBS 1879 (Pz=0.62), in addition to all clinically isolated samples. Evidence of phospholipase activity coincides with results reported by Cafarchia et al (15) and Pini and Faggi (16), who illustrate this enzyme can be involved in pathogenesis, since it acts by hydrolyzing glycerophospholipid ester bonds. Phospholipids and proteins are important host’s plasma membrane compounds. Thus, phospholipase activity induces arachidonic acid liberation, contributing to the inflammatory process through prostaglandin and leukotriene production, resulting in skin pH changes (12). Moreover, it contributes to host epithelial cell membrane disruption through pores formation, favoring tissue colonization (15). Results in this study evidenced M. pachydermatis had the highest phosphatase activity compared to other groups, in agreement with other reports in the literature (15,16).
All clinical isolates as well as M. furfur and M. furfur CBS 7019 reference strain were positive for pigment production in media with tryptophan, as the only nitrogen source. Data in this study corroborate results described by Lang et al (30). Colonies cultured in this media formed dark colonies with diffusible brown pigment after 10 - 12 days of incubation. Similar results have been reported in the literature, since these pigments allow differentiating M. furfur from other species in this genus. However, out of the 38 isolates characterized as M. pachydermatis, 13 produced pigment, five had a faint brown pigmentation in the middle, and eight produced pigment at a different intensity (Figure 1). Recently, it has been reported some M. pachydermatis strains produce pigment (27). Mayser et al (23), evaluated pigment production in M. furfur, M. pachydermatis, and M. sympodialis in different culture media: minimum medium (p-medium) and Dixon agar supplemented with 0.6% L-trp. All M. furfur isolates produced pigment in both media; on the contrary, only one of the M. pachydermatis isolates produced slight pigment in Dixon agar with 0.6% L- trp. Furthermore, in a study carried out by Hossain et al (27), it was observed that 84 M. pachydermatis isolates out of 210 evaluated, produced pigments at variable intensities. In addition, pigment production can be associated with strain genetic variations (26), as observed in this study.
Under physiological conditions M. pachydermatis and M. furfur can proliferate at 37°C and 40°C (13,26). These results permitted to discriminate the presence of species such as M. obtusa, M. restricta, and M. globosa uncapable of growing at 40°C (12).
In conclusion, morphological and biochemical characteristics permitted to identify 36.19% (n=38) of all isolates as M. pachydermatis and 7.62% (n=8) as M. furfur. However, 56.19% (n=59) could not be defined as a specific species. Although it was feasible to classify them within the Malassezia genus based on positive urease activity and morphology; the atypical phenotypical traits of isolates reported as Malassezia spp. could correspond to Malassezia furfur or M. pachydermatis variants. Therefore, a polyphasic strategy incorporating molecular biology tools is required to identify variants within the Malassezia genus.
Conflict of interest
The authors report no conflict of interest.
Acknowledgements
This project was funded by Vicerrectoría de Investigación at Pontificia Universidad Javeriana, grant for research group strengthening 2011, ID PTA 00004585.
References
1. Cafarchia C, Gallo S, Romito D, Capelli G, Otranto D. New insights into the Diagnosis and the Pathogenicity of Malassezia Yeasts. Vet Res commun 2006; 30:231-234.
2. Ashbee H. Update on the genus Malassezia. Med Mycol 2007; 45:287-303.
3. Crespo V, Crespo M, Gómez E. Diagnóstico de laboratorio de las levaduras del género Malassezia. Piel 2008; 23(10):570-576.
4. Torres E, Arenas R, Atoche-Diéguez C. Infecciones causadas por el género Malassezia. Med Cutan Iber Lat Am 2008; 36(6):265-284.
5. Cafarchia C, Gallo S, Capelli G, Otranto D. Occurrence and population size of Malassezia spp. in the external ear canal of dogs and cats both healthy and with otitis. Mycopathologia 2005; 160(2):143-149.
6. Khosravi A, Eidi S, Ziglari T, Bayat M. Isolation and differentiation of Malassezia species isolated from healthy and affected small animals, ear and skin. World J Zool 2008; 3(2):77-80.
7. Angus J. Otic cytology in health and disease. Vet Clin Small Anim 2004; 34(2):411-424.
8. Saridomichelakis M, Farmakit R, Leonidas S, Koutinas A. Aetiology of canine otitis externa: a retrospective study of 100 cases. Vet Dermatol 2007; 18(5):341-347.
9. Zur G, Lifshitz B, Bdolah-Abram T. The association between the signalment, common causes of canine otitis externa and pathogens. J Small Anim Pract 2011; 52(2):254-258.
10. Ginel P, Lucena R, Rodriguez J, Ortega J. A semiquantitative cytological evaluation of normal and pathological samples from the external ear canals of dogs and cats. Vet Dermatol 2002; 13(3):151-156.
11. Guillot J, Breugnot C, De Barros M, Chermette R. Usefulness of modified Dixon’s medium for quantitative culture of Malassezia species from canine skin. J Vet Diagn Invest 1998; 10:384-386
12. Guého-Kellermann E, Boekhout T, Begerow D. Biodiversity, Phylogeny and Ultrastructure. In: Boekhout T, Guého E, Mayser P, Velegraki A. Malassezia and the skin. Science and Clinical Practice, Germany: Springer-Verlag; 2010.
13. Guehó E, Batra R, Boekhout T. Malassezia Baillon (1889). In: Kurtzman CP, Fell JW, Boekhout T. The Yeast a taxonomic study. New York: Elsevier; 2011.
14. Guarro G, Gené J, Stchigel A. Developments in Fungal Taxonomy. Clin Microbiol Rev 1999; 12(3):454-500.
15. Cafarchia C, Otranto D. Association between phospholipase production by Malassezia pachydermatis and skin lesions. J Clin Microbiol 2004; 42(10):4868-4869.
16. Pini G, Faggi E. Extracellular phospholipase activity of Malassezia strains isolated from individuals with and without dermatological disease. Rev Iberoam Micol 2011; 28(4):179-182.
17. Barchmann T, Hort W, Kramer H, Mayser P. Glycine as a regulator of tryptophan-dependent synthesis in Malassezia furfur. Mycoses 2009; 54(1):17-22.
18. Zuther K, Mayser P, Hettwer U, Wu W, Kindler B, Karlovsky P, et al. The tryptophan aminotransferase Tam1 catalyses the single biosynthetic step for tryptophan-dependent pigment synthesis in Ustilago maydis. Mol Microbiol 2008; 68(1):152–172.
19. Mayser P, Haze P, Papavassilis C, Pickel M, Gruender K, Guehó E. Differentiation of Malassezia species: selectivity of Cremophor-EL, castor oil and ricinoleic acid for M. furfur. Brit J Dermatol 1997; 137(2), 208-213.
20. Kindo AJ, Sophia SKC, Kalyani J, Anandan S. Identification of Malassezia species. Indian J Med Microbi 2004; 22(3):179-181.
21. Dos Santos F, Werner S, Pagani B, Dos Santos J. Reclassificacao taxonómica de espécies do genero Malassezia: revisao da literatura sobre as implicacoes clinicolaboratoriais. J Bras Patol Med Lab 2002; 38(3):199-204.
22. Del Río J, Auladell C, Ribes E, Sagristà M, Amor M. Practiques de citología. Ed.1. España: Editorial Universitat de Barcelona. 2005.
23. Mayser P, Wille G, Imkampe A, Thoma W. Synthesis of fluorochromes and pigments is Malassezia by use of tryptophan as the single nitrogen source. Mycoses 1998; 41(7-8):265-271.
24. Coutinho S. Malassezia pachydermatis: enzymes production in isolates from external ear canal of dogs with and without otitis. Arq Bras Med Vet Zootec 2005; 57(2):149-153.
25. Álvarez R. Estadística aplicada a las ciencias de la salud. España: Ediciones Díaz de Santos; 2007.
26. Guillot J, Guehó E, Lesourd M, Midgley G, Chévrier G, Dupont B. Identification of Malassezia species: A practical approach. J Medl Mycol 1996; 6(3):103-110.
27. Hossain H, Landgraf V, Weiss R, Mann M, Hayatpour J, Chakraborty T, et al. Genetic and Biochemical characterization of Malassezia pachydermatis with particular attention to pigment-producing subgroups. Med Mycol 2007; 45(1):41-49.
28. Batra R, Boekhout T, Guého E, Cabañes J, Dawson T, Gupta A. Malassezia Baillon, emerging Clinical Yeasts. FEMS Yeast Research 2005; 5(12): 1101-1113.
29. Cafarchia C, Latrofaa MF, Testinia G, Parisib A, Guillot J, Gasserd RB, et al. Molecular characterization of Malassezia isolates from dogs using three distinct genetic markers in nuclear DNA. Mol Cell Probe 2007; 21(3):229–238
30. Lang S, Hort W, Mayser P. Differentially expressed genes associated with tryptophan-dependent pigment synthesis in Malassezia furfur a comparison with the recently published genome of Malassezia globosa. Mycoses 2009; 54(4):e59-e83.
Author notes
adriana.pulido@javeriana.edu.co